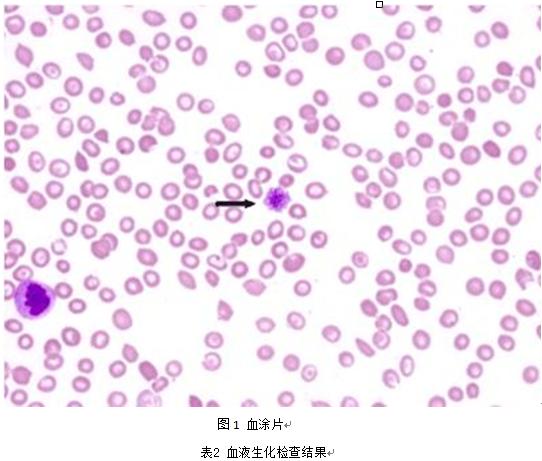
狗狗血液被蜱虫感染怎么治疗,狗狗感染蜱虫会打喷嚏吗

摘要:蜱,也叫壁虱,蛰伏在浅山丘陵的草丛、植物上,或寄宿于牲畜等动物皮毛间。不吸血时,小的才干瘪绿豆般大小,也有如米粒的;吸饱血液后,有饱满的黄豆大小,大的可达指甲盖大。蜱叮咬后会传播无形体病、艾里希体等疾病。其中犬艾利希体是在狗狗身上很常见的一种血液及骨髓的细菌性立克次体类感染的传染性疾病,可导致贫血、免疫力降低及凝血不良。
关键字:蜱虫 艾里希体 紫癜 血小板减少 凝血不良
1 发病情况
贵宾,2Y,雌性,未绝育,正常免疫半年未驱虫。来我院洗澡时美容师发现该犬身体、四肢等部分有大量的皮下出血点和出血斑。病史调查了解到该患犬曾经感染过蜱虫,腰背部瘙抓反射强阳性。
2. 临床检查
T:39.6℃,P:130次/min、R:55次/min 、W:3.6kg,背部、腹部、四肢及尾巴有大量的皮下出血点和出血斑,耳后缘、颈部可见米粒至饱满黄豆粒大小的蜱虫附着,在外观正常皮肤出挤压有针尖样出血点。
3. 辅助检查
3.1血常规检查:可见血小板几乎为0,提示存在出血性疾病或溶血性疾病或血小板生成减少或生成障碍性疾病(表1);
3.2血涂片检查:偶见大血小板,视野内几乎无血小板(图1);
3.3血液生化检查:未见明显异常(表2);
3.4静脉血气检查:未见明显异常(表3);
3.5IDEX四合一检测板检测艾里希体阳性。
表1 血常规检查结果

4分析诊断
患犬血小板数值接近零,集合IDEXX测试版显示艾里希体阳性初步诊断为艾里希体感染。
5治疗与处置
以2.5mg

剂量口服强力霉素,每日两次,加以对症治疗,及时监测患犬血小板数值变化。

6小结与体会
1.该病例虽感染艾里希体,但发现及时未出现白细胞减少、慢性流鼻血、肺出血等病症,该病例得到了较快的治疗而改善了临床症状。
2.艾里希体感染应与其他会引起血小板数值减少的疾病做好鉴别诊断,例如免疫介导性血小板减少症、免疫介导性巨核细胞减少症等,临床上应做到全面检查不遗漏,该病例在就诊过程中还应结合超声检查以及尿液检查加以分析会显得更加完善;
3.艾利希体在环境中保持着由蜱到犬的感染循环,因为犬艾利希体不能在蜱内经卵传播,于是可以通过控制环境中的蜱和消灭计生在犬体表的各个阶段的蜱来清除感染蜱,从而消除艾利希体,所以防止蜱虫感染显得尤为重要,日常的驱虫工作要定期进行。
4.急性艾利希体病犬预后良好,慢性艾利希体预后不确定。如在治疗后数天内由艾利希体引发的发热、出血点、呕吐、腹泻、鼻衄和血小板减少等症状消退,则属于急性艾利希体感染。
5.IDEXX测试版检测仅为艾里希体抗体检测,确诊需要结合细胞学检查、血液学检查等分析结合加以诊断。
6.当疾病发展到严重阶段时,除了对症处理以外还需要采取输血治疗等措施。
网址:http://www.rp-pet.com/rmgjcgl/1014.html